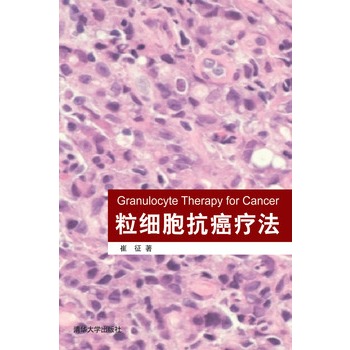

|
|
|
|
| 《粒细胞抗癌疗法(电子书)》 |
| 作者:崔征 |
| 出版社:清华大学出版社 |
出版日期:2013/2/23 |
| ISBN:9787302265542 |
定价: 30.00元 |
|
内容推荐
本书是当今所有疾病中最令人生畏的,正取代心血管疾病成为人类健康的第一杀手。癌症治疗的关键是将癌细胞杀死但又不伤害正常细胞,为此,人类已经付出200多年的努力,但现有的抗癌疗法仍存在着各种不足。癌症一旦转移扩散,所有常规疗法都束手无策。《粒细胞抗癌疗法》以通俗的形式介绍了抗癌领域的研究背景和进展,着重介绍了作者主持研发的全新的粒细胞抗癌疗法(又称粒福特疗法)的来由、现状及应用前景。粒福特疗法起源于11年前抗癌小白鼠的意外发现。对抗癌小鼠的长期研究及随后对各种患者的最新研究提示,一种不伤害正常细胞但又能高效杀死癌细胞的活性客观存在于长期被人们忽视的粒细胞中。这种抗癌活性不仅为健康人提供高效免疫监控体系,同时还可以通过成分采血的方式成为抗癌生物制剂,继而用于癌症患者的治疗。我们的临床预试验显示,从供体中采集出的有高抗癌活性的粒细胞对某些晚期癌症具有“药”到病除的奇效,这样一种全新的、高效无毒的粒细胞抗癌疗法有望为癌症患者带来新的希望。
作者简介
崔征,男,1956年出生于辽宁省大连市。美国威克·弗里斯特(Wake Forest,又译为维克·森林)大学医学院终身教授,中国同济大学先进材料与纳米生物医学研究院特聘教授。“文革”期间随父母内迁至贵州省遵义市,高中毕业后“上山下乡”;1976年进入遵义医学院医疗系;1981年考入中科院上海分院,主攻昆虫生物化学;1982年考入美国马萨诸塞大学,主修生物化学,1987年获生物化学博士学位;同年,以博士后身份进入美国哈佛大学医学院,师从Eva Neer,研究真核细胞间的信息传导。1990年,应聘于加拿大阿尔伯塔大学生物化学系,研究肝脏磷脂代谢调控。1996年,应聘于美国威克·弗里斯特大学医学院生物化学系,开始独立领军的研究生涯。迄今为止,已发表近60篇研究论文(包括综述及图书章节),兼任多家国际生物化学杂志编委。近年来,在国际学术大会上的多次演讲及一些学术论文的发表受到广泛的重视。作者及其团队在抗癌领域的创新工作,特别是作者首创的粒细胞抗癌疗法已经得到国际主流媒体、癌症研究者和众多癌症患者的强烈关注。作者首创的这一疗法已获得美国卫生部药检局的批准,正在进行一期及二期临床试验。
目录
封面
扉页
版权页
内容提要
目录
1 概述
1.1 发达国家癌症流行病学概况
1.2 中国癌症流行病学概况
1.3 抗癌领域进展的评估
1.4 5年存活率的影响因素
1.5 癌症的病因
1.6 癌症的分类
1.7 癌症致死的原因
1.8 癌症细胞学的特点
1.9 癌生长与新血管生成的关系
1.10 癌细胞向周围组织浸润扩散的特点
1.11 抗癌疗法概况
2 癌症的免疫监控
3 抗癌小鼠
3.1 抗癌小鼠的意外发现
3.2 粒细胞的参与
3.3 抗癌机制的遗传学及基因组学
4 体外杀癌活性的定量检测
4.1 抗癌小鼠
4.2 人体
5 人体粒细胞及其在临床上的应用
6 粒细胞的效应机制及靶向
7 癌细胞是粒细胞的靶子
8 抗癌人
9 传统过继免疫疗法
10 细菌感染及癌症消退
11 粒细胞可根治癌症
参考文献
封底
|
|
|